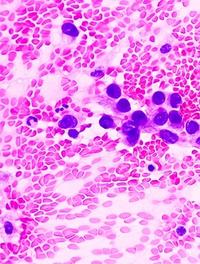

Cancer oligométastatique oligoprogressif : l’apport de la radiothérapie stéréotaxique corporelle
La radiothérapie stéréotaxique corporelle (RSC) consiste en une irradiation tumorale sélective guidée par l’imagerie en temps réel. Elle vise en règle des tumeurs primaires ou secondaires dont les dimensions n’excèdent pas 5 cm, le plus souvent isolées sans envahissement ganglionnaire. Elle permet de délivrer avec une précision millimétrique des rayons X de haute énergie sous la forme de mini-faisceaux multiples, généralement non coplanaires, des doses élevées fractionnées [...]